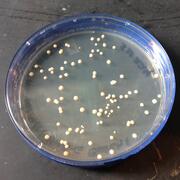
Bacterial colonies (mycobacteria) growing on artificial media in a petri plate.

Common terms used within the Environmental Health Program
0-9

6PPD
6PPD
A chemical compound used as an antioxidant and stabilizer in rubber products, particularly in tires, to prevent degradation from heat and oxidation.
6PPD-quinone
6PPD-quinone
A chemical compound that is a transformation product of 6PPD (N- (1,3-dimethylbutyl)-N'-phenyl-p-phenylenediamine), which is commonly used as an antioxidant in rubber products, particularly in tires.
A
Abiotic
Abiotic
Referring to non-living components of the environment, such as water, temperature, soil, and light, that influence ecosystems and the organisms within them.
Agricultural Runoff
Agricultural Runoff
Water that carries fertilizers, pesticides, and other chemicals from agricultural lands into nearby water bodies.
Air Quality Index (AQI)
Air Quality Index (AQI)
A measure used to communicate how polluted the air currently is or how polluted it is forecast to become.

Algae
Algae
Simple, often microscopic organisms that can photosynthesize; some species can bloom excessively and cause harm.

Algal Bloom
Algal Bloom
A phenomenon characterized by the excessive growth of algae in water bodies, typically triggered by nutrient overload, which can lead to discoloration of the water.
Algal Toxins
Algal Toxins
Substances produced by certain algae that can have detrimental effects on health and the environment.
Amino Acid
Amino Acid
The building blocks of proteins, consisting of a central carbon atom, an amino group, a carboxyl group, and a variable side chain.
Anthropogenic
Anthropogenic
Referring to effects, processes, or materials that are derived from human activity, particularly concerning environmental changes.
Antibiotic
Antibiotic
A type of medication used to treat bacterial infections by killing or inhibiting the growth of bacteria.
Antibiotic Resistance
Antibiotic Resistance
The ability of bacteria to resist the effects of an antibiotic that they were once sensitive to, making the antibiotic less effective or ineffective.
Antibiotic Resistance Genes
Antibiotic Resistance Genes
Genetic material that allows bacteria to survive exposure to antibiotics, often linked to the presence of pharmaceuticals in the environment.
Antigenic Drift
Antigenic Drift
A gradual change in the virus's surface proteins over time, which can affect vaccine effectiveness and the virus's ability to evade the immune response.
Antigenic Shift
Antigenic Shift
A major change in the virus's surface proteins that can lead to new strains of avian influenza, potentially increasing the risk of human infection.
Antimicrobial
Antimicrobial
A broader term that includes antibiotics as well as other substances that kill or inhibit the growth of microorganisms, including fungi and viruses, and parasites.
Antioxidant
Antioxidant
A substance that inhibits oxidation and helps protect materials from degradation due to exposure to oxygen and heat.
Aquatic Toxicity
Aquatic Toxicity
The harmful effects of a substance on aquatic organisms, which can result from exposure to contaminated water.
Aquifer
Aquifer
A geological formation that can store and transmit water, providing a source for wells and springs.
Archaea
Archaea
A group of single-celled microorganisms that are distinct from bacteria and eukaryotes; they often thrive in extreme environments.
Avian Influenza
Avian Influenza
A viral infection that primarily affects birds but can also infect humans and other animals; commonly known as bird flu.
B
Bacteria
Bacteria
Single-celled microorganisms that can be found in various environments; they can be beneficial or harmful to humans and other organisms.
Bactericidal
Bactericidal
Antibiotics that kill bacteria directly.
Bacteriostatic
Bacteriostatic
Antibiotics that inhibit the growth and reproduction of bacteria without killing them.
Base Pairing
Base Pairing
The specific hydrogen bonding between nitrogenous bases in DNA (adenine with thymine, and cytosine with guanine) or RNA (adenine with uracil).
Bioaccumulation
Bioaccumulation
The process by which organisms accumulate contaminants in their bodies over time, potentially leading to higher concentrations in the food chain.
Biodegradation
Biodegradation
The process by which microorganisms break down a chemical compound into simpler, less harmful substances.
Biofilm
Biofilm
A complex community of microorganisms that adhere to surfaces and are embedded in a protective matrix; biofilms can form on natural and artificial surfaces.
Bioinformatics
Bioinformatics
The application of computational tools and techniques to analyze and interpret biological data, particularly in omics studies.
Biomarker
Biomarker
A biological molecule or characteristic that can be measured and evaluated as an indicator of a biological process, condition, or disease.
Biomonitoring
Biomonitoring
The assessment of the health of ecosystems and the impact of pollutants through the monitoring of biological indicators or species. This can be done by measuring levels of chemicals or their metabolites in biological specimens (e.g., blood, urine) to assess exposure to environmental contaminants.
Bioremediation
Bioremediation
The use of living organisms, such as bacteria, to remove or neutralize contaminants from a polluted area.
Biosecurity
Biosecurity
Measures and protocols designed to prevent the introduction and spread of harmful biological agents, including pathogens and invasive species, in humans, animals, and ecosystems.

Biosolid
Biosolid
A nutrient-rich organic material resulting from the treatment of sewage sludge, which is the solid byproduct of wastewater treatment.
Biotic
Biotic
Relating to living organisms and their interactions within ecosystems, including plants, animals, microorganisms, and their effects on the environment.
Broad-Spectrum Antibiotic
Broad-Spectrum Antibiotic
An antibiotic that is effective against a wide range of bacteria, including both Gram-positive and Gram-negative bacteria.
C
Carbon Footprint
Carbon Footprint
The total amount of greenhouse gases emitted directly or indirectly by an individual, organization, or product throughout its life cycle.
Chemical Exposure
Chemical Exposure
The contact of living organisms with a chemical substance, which can occur through various pathways, including inhalation, ingestion, or dermal contact.
Chemical Regulation
Chemical Regulation
The laws and guidelines governing the use, handling, and disposal of chemical substances to protect human health and the environment.
Chromosome
Chromosome
A structure composed of DNA and proteins that carries genetic information; humans have 23 pairs of chromosomes.
Climate Change
Climate Change
Long-term changes in temperature, precipitation, and other atmospheric conditions on Earth, often linked to human activities.
Climate Resilience
Climate Resilience
The ability of land management practices to adapt to and mitigate the impacts of climate change, ensuring the sustainability of ecosystems and communities.
Clinical Signs
Clinical Signs
Clinical signs are visible signs of a disease or medical condition that can be seen during a visually or through tests. They include observations of changes in vital signs or physical appearance. Clinical signs help us track how a disease is progressing.
Clostridium difficile (C. diff)
Clostridium difficile (C. diff)
A bacterium that can cause severe diarrhea and is often associated with antibiotic use, particularly when normal gut bacteria are disrupted.
Community-Based Land Management
Community-Based Land Management
An approach that involves local communities in the decision-making process regarding land use and management, promoting sustainable practices.
Comparative Genomics
Comparative Genomics
The analysis of the similarities and differences in the genomes of different species to understand evolutionary relationships and functional elements.
Condensation
Condensation
The conversion of water vapor back into liquid water, forming clouds and precipitation.
Confined Aquifer
Confined Aquifer
An aquifer that is sandwiched between layers of impermeable rock or clay, restricting water movement and often resulting in increased pressure.
Conservation
Conservation
The protection, preservation, and management of natural resources and ecosystems to prevent degradation and ensure their sustainability.
Contaminant
Contaminant
Any substance that can cause harm to the environment or human health, including chemicals, pathogens, and physical agents.
Contaminants
Contaminants
Substances that can cause harm to the environment or human health, including chemicals, pathogens, and physical agents.
Contaminants of Emerging Concern (CECs)
Contaminants of Emerging Concern (CECs)
Substances that are not commonly monitored but may have the potential to cause adverse environmental and health effects, often due to their increasing detection in the environment.
Contaminated Sites
Contaminated Sites
Locations where contaminants have been detected in soil, water, or air.
CRISPR (Clustered Regularly Interspaced Short Palindromic Repeats)
CRISPR (Clustered Regularly Interspaced Short Palindromic Repeats)
A revolutionary gene-editing technology that allows for precise modifications of DNA in living organisms.
Culture
Culture
The process of growing microorganisms in a controlled environment, typically in a laboratory setting, to study their characteristics.
Culture and Sensitivity Testing
Culture and Sensitivity Testing
Laboratory tests that determine the type of bacteria causing an infection and which antibiotics are effective against it.
Cyanobacteria
Cyanobacteria
Commonly known as blue-green algae, are a group of photosynthetic bacteria that thrive in a variety of aquatic environments, including freshwater, marine water, and moist soils.
D
Data Integration
Data Integration
The process of combining data from different omics studies to provide a more comprehensive understanding of biological systems.
Decommissioning
Decommissioning
The process of safely closing and dismantling energy production facilities, such as power plants or oil rigs, at the end of their operational life.
Degradation Products
Degradation Products
Substances that result from the breakdown of a chemical compound, which can sometimes be more harmful than the original substance.
Direct Transmission
Direct Transmission
The spread of diseases through direct contact between infected and susceptible individuals, such as bites or body fluid.
Discharge
Discharge
The flow of groundwater from an aquifer to the surface, often observed in springs and rivers.
DNA (Deoxyribonucleic Acid)
DNA (Deoxyribonucleic Acid)
The molecule that carries genetic information in living organisms, composed of two strands forming a double helix.
Drainage Basin
Drainage Basin
An area of land where all rainfall and runoff flow into a common outlet, such as a river, lake, or ocean.
Drilling
Drilling
The process of creating holes in the ground to obtain samples for exploration or to extract minerals.
Drinking Water Standards
Drinking Water Standards
Drinking water standards are regulations and guidelines set by government agencies to ensure that water intended for human consumption is safe and free from harmful contaminants. These standards specify the maximum allowable levels of various pollutants, such as bacteria, chemicals, and heavy metals, in drinking water.
E
Ecosystem
Ecosystem
A community of living organisms and their physical environment interacting as a system.
Ecosystem Services
Ecosystem Services
The benefits that humans obtain from ecosystems, including provisioning (food, water), regulating (climate control, flood regulation), cultural (recreational, aesthetic), and supporting services (nutrient cycling, pollination).
Ecotoxicology
Ecotoxicology
The study of the effects of toxic substances on ecosystems and the organisms within them, including the assessment of chemical impacts on wildlife.
Emerging Infectious Disease
Emerging Infectious Disease
Newly appearing or evolving diseases in wildlife populations, which may pose risks to other species or humans.
Endocrine Disruptors
Endocrine Disruptors
Chemicals that can interfere with hormonal systems, potentially leading to developmental, reproductive, and other health issues in humans and wildlife.
Energy Efficiency
Energy Efficiency
The practice of using less energy to provide the same service or output, often achieved through technology improvements or behavioral changes.
Energy Resource
Energy Resource
Any natural resource that can be converted into energy, including fossil fuels, renewable sources, and nuclear materials.
Energy Transition
Energy Transition
The shift from traditional fossil fuel-based energy systems to more sustainable and renewable energy sources.
Environmental Exposure
Environmental Exposure
Contact with environmental contaminants through air, water, soil, or food.
Environmental Impact
Environmental Impact
The effect that an energy resource's life cycle has on the environment, including air and water pollution, habitat destruction, and climate change.
Environmental Impact Assessment (EIA)
Environmental Impact Assessment (EIA)
Process used to evaluate the potential environmental effects of a proposed project or development before it is undertaken. The purpose of an EIA is to identify, predict, and assess the likely environmental impacts—both positive and negative—of a project, and to consider alternative options and mitigation measures to lessen adverse impacts.
Environmental Monitoring
Environmental Monitoring
The systematic collection and analysis of environmental samples to detect the presence and concentration of contaminants, including CECs.
Environmental Persistence
Environmental Persistence
The ability of a chemical compound to remain in the environment for an extended period without breaking down.
Enzyme
Enzyme
A type of protein that acts as a catalyst to accelerate biochemical reactions without being consumed in the process.
Epidemiology
Epidemiology
The study of how diseases spread and affect populations, including factors influencing wildlife health and disease transmission.
Epigenomics
Epigenomics
The study of the complete set of epigenetic modifications on the genetic material of a cell, which can influence gene expression without altering the DNA sequence.
Eutrophication
Eutrophication
A process where excess nutrients, lead to algal blooms that deplete oxygen in water bodies.
Evaporation
Evaporation
The process by which water changes from a liquid to a vapor, typically from surfaces like oceans, lakes, and rivers.
Exploration
Exploration
The phase of mining research that involves searching for mineral deposits and assessing their potential for extraction.
Exposure Assessment
Exposure Assessment
The process of measuring or estimating the intensity, frequency, and duration of human exposure to an environmental agent.
Exposure Pathway
Exposure Pathway
The route taken by a contaminant from its source to the receptor, including air, water, or soil; it encompasses the mechanism of transfer.
Extraction
Extraction
The process of obtaining energy resources from the earth, such as drilling for oil or mining for coal.
F
Fermentation
Fermentation
A metabolic process that converts sugars to acids, gases, or alcohol using microorganisms, commonly used in food production.
Field Measurements
Field Measurements
Process of collecting data and observations directly in the natural environment, as opposed to in a controlled setting like a laboratory. This can include various types of measurements such as temperature, pressure, soil quality, and other environmental parameters, depending on the specific field of study.
Firefighting Foam
Firefighting Foam
A type of foam used to extinguish flammable liquid fires, often containing PFAS, which can lead to environmental contamination.
Floodplain
Floodplain
The area adjacent to a river or stream that is prone to flooding during periods of high water.
Fluorinated Compounds
Fluorinated Compounds
Chemicals that contain fluorine atoms, including PFAS, which are known for their resistance to degradation.
Food Web
Food Web
A complex network of feeding relationships among organisms in an ecosystem, highlighting how energy and nutrients flow through the community.
Fossil Fuels
Fossil Fuels
Natural substances formed from the remains of ancient plants and animals, including coal, oil, and natural gas.
Functional Genomics
Functional Genomics
The study of the relationship between genes and their functions, often using techniques to manipulate gene expression and observe the effects.
Fungi
Fungi
A group of eukaryotic organisms that includes yeasts, molds, and mushrooms; they play essential roles in decomposition and nutrient cycling.
G
Gel Electrophoresis
Gel Electrophoresis
A laboratory method used to separate DNA, RNA, or proteins based on their size and charge, allowing for analysis and identification.
Gene
Gene
A segment of DNA that contains the instructions for synthesizing a specific protein or RNA molecule, serving as the basic unit of heredity.
Gene Expression
Gene Expression
The process by which information from a gene is used to synthesize a functional gene product, typically a protein, and can be regulated at various stages.
Genomics
Genomics
The study of the complete set of DNA (the genome) in an organism, including its structure, function, evolution, and mapping.
Geochemical Analysis
Geochemical Analysis
The study of the chemical composition of earth materials to identify and quantify minerals and elements.
Geology
Geology
The study of the earth's physical structure, substance, history, and processes, which is crucial for understanding mineral deposits.
Geophysical Survey
Geophysical Survey
A method used to investigate the physical properties of the earth's subsurface, often used in mineral exploration.
Groundwater
Groundwater
Water that is found beneath the Earth's surface in soil pore spaces and fractures of rock formations, contributing to aquifers and influencing surface water bodies.
H
H5N1
H5N1
A highly pathogenic strain of avian influenza virus that has caused severe disease in birds and has been associated with human infections.
H7N9
H7N9
A strain of avian influenza that has been linked to human infections, and is known for its potential to cause severe respiratory illness.
Habitat
Habitat
The natural environment where an organism resides, comprising both biotic and abiotic factors.

Harmful algal blooms
Harmful algal blooms
A rapid increase in algae in water bodies that can produce toxins harmful to aquatic life, animals, and humans. These blooms can deplete oxygen levels in the water, leading to dead zones and negatively impacting aquatic ecosystems.
Hazard
Hazard
A potential source of harm or adverse effect on health or the environment.
Health Advisory Levels
Health Advisory Levels
Guidelines issued by health agencies, such as the EPA, to inform the public about safe levels of specific contaminants in drinking water.
Health Effects
Health Effects
Refers to the changes in health status or well-being that result from exposure to various factors, including environmental pollutants, chemicals, or infectious agents.
Health Risk Assessment
Health Risk Assessment
A systematic process to evaluate the potential health risks associated with exposure to hazardous substances.
Heavy Metals
Heavy Metals
Metallic elements such as lead, mercury, and cadmium that can be toxic to humans and wildlife, often accumulating in the food chain.
High-Throughput Sequencing
High-Throughput Sequencing
A technology that allows for the rapid sequencing of large amounts of DNA or RNA, enabling comprehensive genomic and transcriptomic analyses.
Horizontal Gene Transfer
Horizontal Gene Transfer
The process by which bacteria can exchange genetic material, including antibiotic resistance genes, with one another.
Hydrological Model
Hydrological Model
A mathematical representation of the hydrologic cycle, used to simulate and predict water movement within an area.
Hydrology
Hydrology
The scientific study of water, its properties, distribution, movement, and the water cycle within the environment.
Hydrometallurgy
Hydrometallurgy
A method for extracting metals from ores using aqueous solutions.
I
IHNV
IHNV
Infectious hematopoietic necrosis virus: A serious fish disease affecting salmon and trout in the Pacific Northwest. It mainly harms young fish by attacking their internal organs and can cause high death rates, especially in hatcheries. The virus spreads easily through water and between fish, and declines in fish populations can disrupt entire aquatic ecosystems and harm indigenous and local communities that rely on healthy fish populations, affecting both commercial and recreational fishing industries.
Immunomodulation
Immunomodulation
The process of altering or regulating the immune response, which can enhance or suppress immune function.
Indirect Transmission
Indirect Transmission
The spread of infectious agents from one host to another through an intermediary object, organism, or environment, rather than through direct contact.
Industrial Discharges
Industrial Discharges
Waste materials and pollutants released from factories and plants into the air, water, or soil.
Infection
Infection
The invasion and multiplication of pathogenic microorganisms in a host organism, leading to disease.
Infection Control
Infection Control
Practices aimed at preventing the spread of infections.
Infectious Disease
Infectious Disease
Diseases caused by pathogenic organisms that spread between animals or from animals to humans, such as rabies or avian influenza.
Infectious hematopoietic necrosis virus
Infectious hematopoietic necrosis virus
A serious fish disease affecting salmon and trout in the Pacific Northwest. It mainly harms young fish by attacking their internal organs and can cause high death rates, especially in hatcheries. The virus spreads easily through water and between fish, and declines in fish populations can disrupt entire aquatic ecosystems and harm indigenous and local communities that rely on healthy fish populations, affecting both commercial and recreational fishing industries.
Infiltration
Infiltration
The process by which water on the ground surface enters the soil, recharging groundwater supplies.
Inoculation
Inoculation
The introduction of a microbe into a culture medium or host organism to initiate growth or infection.
Integrated Land Use Management
Integrated Land Use Management
A holistic approach that considers the interconnections between land, water, and other natural resources to optimize their use and minimize conflicts.
L
Land Management
Land Management
The process of managing the use and development of land resources to meet various economic, social, and environmental objectives.
Land Restoration
Land Restoration
The process of rehabilitating degraded land to restore its ecological health and productivity, often involving reforestation or soil improvement techniques.
Land Use Change
Land Use Change
The transformation of land from one use to another, such as converting forests to agricultural land or urban development.
Land Use Planning
Land Use Planning
The process of evaluating and designating how land should be used for various purposes, such as residential, commercial, agricultural, and recreational activities.
Landfills
Landfills
Sites for the disposal of waste that can leach contaminants into the soil and groundwater.
LARMS (Land and Resource Management System)
LARMS (Land and Resource Management System)
Refers to a comprehensive framework or system designed to manage land and natural resources effectively. It typically involves the integration of various data sources, technologies, and practices to monitor, assess, and optimize the use of land and resources.
Life Cycle Assessment (LCA)
Life Cycle Assessment (LCA)
Systematic method for evaluating the environmental impacts of a product, process, or service throughout its entire life cycle. This includes all stages from raw material extraction, production, and use, to disposal or recycling. LCA aims to identify and quantify the environmental effects associated with each phase, such as energy consumption, resource depletion, emissions, and waste generation.
Lifecycle Emissions
Lifecycle Emissions
The total greenhouse gas emissions produced throughout the entire life cycle of an energy resource, from extraction to disposal.
Long-Chain PFAS
Long-Chain PFAS
A subgroup of PFAS characterized by a long carbon chain (typically containing eight or more carbon atoms) and a functional group that provides water and grease resistance. Long-chain PFAS are known for their persistence in the environment.
M
Metabolomics
Metabolomics
The comprehensive analysis of metabolites, which are small molecules involved in metabolic processes, providing insights into cellular processes and metabolic pathways.
Methicillin-Resistant Staphylococcus aureus (MRSA)
Methicillin-Resistant Staphylococcus aureus (MRSA)
A strain of Staphylococcus aureus that is resistant to methicillin and other common antibiotics, making it difficult to treat.
Methylmercury
Methylmercury
Any of various toxic compounds of mercury containing the complex CH3Hg– that often occur as pollutants which accumulate in living organisms (as fish) especially in higher levels of a food chain.
Microbe
Microbe
A microscopic organism, which can be a bacterium, virus, fungus, or protozoan, that is typically too small to be seen with the naked eye.
Microbiome
Microbiome
The collection of microorganisms, including bacteria, viruses, fungi, and protozoa, that inhabit a specific environment, such as the human gut.
Microbiomics
Microbiomics
The study of the collective genomes of the microorganisms (microbiota) residing in a specific environment, such as the human gut.
Microplastics
Microplastics
Small plastic particles (<5 mm in size) that result from the breakdown of larger plastic items and can accumulate in the environment, posing risks to aquatic organisms and ecosystems.
Mine Closure
Mine Closure
The process of shutting down a mining operation and rehabilitating the site to minimize environmental impact.
Mine Safety
Mine Safety
The practices and regulations designed to protect the health and safety of workers in mining operations.
Mineral
Mineral
A naturally occurring inorganic substance with a definite chemical composition and crystalline structure.
Mineral Processing
Mineral Processing
The process of separating valuable minerals from the ore to produce a concentrate.
Minimum Inhibitory Concentration (MIC)
Minimum Inhibitory Concentration (MIC)
The lowest concentration of an antibiotic that prevents the growth of a specific bacterium.
Mining
Mining
The process of extracting valuable minerals or other geological materials from the earth.
Mitigation
Mitigation
Actions taken to reduce or eliminate the adverse effects of environmental hazards.
Molecular Biology
Molecular Biology
The branch of biology that studies the molecular mechanisms of biological processes, particularly the interactions between DNA, RNA, proteins, and their biosynthesis.
Mutation
Mutation
A change in the DNA sequence that can lead to alterations in gene function and may result in genetic diversity or disease.
N
Nanomaterials
Nanomaterials
Engineered materials at the nanoscale that may have unique properties and potential environmental and health impacts not fully understood.
Nanoplastic
Nanoplastic
Tiny plastic particles that are less than 1 micrometer (1,000 nanometers) in size. These particles can originate from the breakdown of larger plastic debris or can be intentionally manufactured for various applications, such as in cosmetics and industrial processes.
Nanoplastics
Nanoplastics
Are a concern due to their potential to enter the environment, accumulate in food chains, and pose health risks to humans and wildlife, as their small size allows them to penetrate biological membranes and tissues.
Narrow-Spectrum Antibiotic
Narrow-Spectrum Antibiotic
An antibiotic that is effective against a specific group of bacteria.
Non-Infectious Disease
Non-Infectious Disease
Diseases not caused by pathogens, often resulting from environmental factors, genetic defects, or nutritional deficiencies (e.g., lead poisoning, habitat degradation).
Nucleotide
Nucleotide
The basic building block of nucleic acids (DNA and RNA), consisting of a sugar, a phosphate group, and a nitrogenous base.
O
Omics
Omics
A collective term for fields of study in biology that involve the comprehensive analysis of biological molecules, including genomics, proteomics, metabolomics, and others.
Open-Pit Mining
Open-Pit Mining
A surface mining technique where a large excavation is made to extract minerals near the surface.
Ore
Ore
A type of rock that contains sufficient minerals with important elements, such as metals, that can be economically extracted.
Outbreak
Outbreak
A sudden increase in the number of cases of avian influenza in a specific area, often leading to significant health and economic impacts.
P
Pathogen
Pathogen
A microbe that can cause disease in its host, including bacteria, viruses, fungi, and protozoa that can cause diseases in humans, animals, or plants.
Pathogenicity
Pathogenicity
The ability of a microbe to cause disease in a host organism.
Pathogens
Pathogens
Microorganisms, such as bacteria or viruses, fungi, and protozoa that can cause diseases in humans, animals, or plants.
PCR (Polymerase Chain Reaction)
PCR (Polymerase Chain Reaction)
A technique used to amplify specific DNA sequences, making millions of copies of a particular segment of DNA.
Per- and Polyfluoroalkyl Substances
Per- and Polyfluoroalkyl Substances
A group of synthetic chemicals that are characterized by a carbon-fluorine bond, which makes them resistant to water, oil, and heat. PFAS are used in a wide range of applications, including waterproofing, nonstick coatings, and firefighting foams. These substances are often referred to as "forever chemicals" due to their persistence in the environment and the human body, leading to concerns about potential health effects
Per- and Polyfluoroalkyl Substances (PFAS)
Per- and Polyfluoroalkyl Substances (PFAS)
A group of synthetic chemicals that are characterized by a carbon-fluorine bond, which makes them resistant to water, oil, and heat. PFAS are used in a wide range of applications, including waterproofing, nonstick coatings, and firefighting foams. These substances are often referred to as "forever chemicals" due to their persistence in the environment and the human body, leading to concerns about potential health effects.
Perfluorooctanesulfonic Acid
Perfluorooctanesulfonic Acid
Another specific PFAS that has been used in firefighting foams and stain-resistant fabrics; it is also being phased out due to health risks.
Perfluorooctanoic Acid
Perfluorooctanoic Acid
A specific type of PFAS that has been widely used in the production of non-stick cookware and other products; it is now largely phased out due to health concerns.
Permeability
Permeability
The ability of a material to transmit water through its pores or fractures.
Personal Care Products
Personal Care Products
Items such as cosmetics, soaps, and lotions that can contain chemicals that may be harmful to the environment when washed off.
Pesticides
Pesticides
Chemicals used to kill or control pests that can contaminate water and soil, leading to potential risks for non-target organisms.
Phage Therapy
Phage Therapy
A treatment that uses bacteriophages (viruses that infect bacteria) to target and kill antibiotic-resistant bacteria.
Pharmaceuticals
Pharmaceuticals
Medications that can enter the environment through various pathways, such as wastewater, and may affect aquatic life and human health.
Plankton
Plankton
Microscopic organisms that drift in water bodies, including phytoplankton (plant-like) and zooplankton (animal-like), which serve as a vital part of aquatic food webs.
Plasmid
Plasmid
A small, circular piece of DNA found in bacteria that can replicate independently of chromosomal DNA. Plasmids often carry genes that can provide beneficial traits, such as antibiotic resistance, and facilitate the transfer of these traits between bacteria through processes like horizontal gene transfer. This ability plays a significant role in the evolution of bacterial populations and their adaptability to environmental pressures, including the presence of antibiotics.
Policy Framework
Policy Framework
The set of laws, regulations, and incentives that govern the development, production, and consumption of energy resources.

Pollinator
Pollinator
An organism, often an insect like a bee or butterfly, that transfers pollen from the male structures of flowers to the female structures, facilitating fertilization and the production of seeds and fruit.

Pollinators
Pollinators
Organisms, often insects like a bee or butterfly, that transfers pollen from the male structures of flowers to the female structures, facilitating fertilization and the production of seeds and fruit.
Pollutant
Pollutant
A substance that contaminates the environment and can cause harm to human health or ecosystems.
Pollution
Pollution
The introduction of harmful substances or products into the environment, resulting in adverse effects.
Porosity
Porosity
The measure of the void spaces in a material, indicating its ability to store water.
Poultry
Poultry
Domesticated birds raised for food, such as chickens, ducks, and turkeys, which can be affected by avian influenza.
Precipitation
Precipitation
Any form of water, liquid or solid, that falls from the atmosphere to the Earth's surface, including rain, snow, sleet, and hail.
Probiotics
Probiotics
Live microorganisms that provide health benefits when consumed in adequate amounts, often found in fermented foods.
Protein
Protein
A large, complex molecule made up of amino acids that performs various functions in the body, including catalyzing biochemical reactions and providing structural support.
Proteomics
Proteomics
The large-scale study of proteins, particularly their functions, structures, and interactions within a biological system.
Protozoa
Protozoa
Single-celled eukaryotic organisms that can be free-living or parasitic; they are often found in water and soil.
Public Health Impact
Public Health Impact
The potential effects of a contaminants on human health, which can include acute and chronic health issues resulting from exposure.
Q
Quarantine
Quarantine
The Practice that involves isolating individuals, animals, or goods that may have been exposed to a contagious disease to prevent its spread.
R
Receptor
Receptor
An entity that can be affected by a pollutant or contaminant, typically people, wildlife, or natural resources (e.g., water bodies, soil).
Recharge
Recharge
The process by which water infiltrates into an aquifer, replenishing groundwater supplies.
Reclamation
Reclamation
The process of restoring land that has been mined to a natural or economically usable state.
Regulatory Assessment
Regulatory Assessment
The evaluation of a chemical's safety and environmental impact by regulatory agencies, which may lead to guidelines or restrictions on its use.
Regulatory Framework
Regulatory Framework
The set of laws and regulations governing the monitoring, management, and remediation of contaminants of emerging concern.
Remediation
Remediation
The process of cleaning up or removing contaminants from the environment.
Remote Sensing
Remote Sensing
The use of satellite and aerial imagery to obtaining information about an object or area from a distance.
Renewable Energy
Renewable Energy
Energy derived from natural processes that are replenished constantly, such as solar, wind, hydro, and geothermal energy.
Replication
Replication
The process by which DNA is copied to produce two identical copies, ensuring genetic information is passed on during cell division.
Reservoir
Reservoir
An artificial lake created by damming a river to store water for various uses such as irrigation, drinking, and flood control.
Resource Estimation
Resource Estimation
The process of calculating the quantity and quality of mineral resources in a given area.
Restoration
Restoration
The process of returning a degraded, damaged, or altered ecosystem, habitat, or resource to its original condition or a stable, healthy state. This can involve various activities, such as rehabilitating natural landscapes, reintroducing native species, removing pollutants, and restoring natural processes.
Risk Assessment
Risk Assessment
The process of evaluating the potential health risks associated with exposure to a chemical, including its toxicity and environmental impact.
RNA (Ribonucleic Acid):
RNA (Ribonucleic Acid):
A single-stranded molecule involved in various biological roles, including the transmission of genetic information and the synthesis of proteins.
Runoff
Runoff
Water that flows over the land surface and returns to water bodies, typically after precipitation events.
S
Sediment Contamination
Sediment Contamination
The presence of harmful substances in sediment, which can affect aquatic ecosystems and the organisms that inhabit them.
Short-Chain PFAS
Short-Chain PFAS
A subgroup of PFAS that typically contains fewer than six carbon atoms in their molecular structure. These substances are often considered to have a lower environmental persistence than long-chain PFAS, but they may still pose potential health risks.
Single-Cell Omics
Single-Cell Omics
Techniques that allow for the analysis of individual cells, providing insights into cellular heterogeneity and specific cellular functions.
Soil Erosion
Soil Erosion
The removal of the top layer of soil by wind, water, or human activity, which can lead to loss of soil fertility and degradation of land.
Source
Source
The origin or point of release of a pollutant or contaminant in the environment, such as factories, agricultural fields, or natural disasters.
Source Control
Source Control
Strategies aimed at reducing or eliminating the introduction of contaminants into the environment, particularly at their source.
Source Identification
Source Identification
The process of determining the origins of contamination, which can include industrial discharges, firefighting foam use, and consumer products.

Source-to-Receptor
Source-to-Receptor
Framework that describes the pathway through which contaminants travel from their origin (the source) to the target or affected entity (the receptor).
Sterilization
Sterilization
The process of eliminating all forms of microbial life, including bacteria, viruses, fungi, and spores, from an object or environment.
Streamflow
Streamflow
The flow of water in a natural or artificial stream, measured in cubic feet per second (cfs) or cubic meters per second (cms).
Succession
Succession
The process of change in the species structure of an ecological community over time, which can be primary (starting from bare substrate) or secondary (following disturbance).
Superbug
Superbug
A term used to describe bacteria that have become resistant to multiple antibiotics, making them difficult to treat.
Surveillance
Surveillance
The systematic monitoring and continuous collection, analysis, and interpretation of data related to health events, behaviors, or conditions within a population.
Sustainable Agriculture
Sustainable Agriculture
Farming practices that maintain soil health, conserve water, and promote biodiversity while producing food and other agricultural products.
Sustainable Land Management (SLM)
Sustainable Land Management (SLM)
Practices that aim to balance land use with environmental health, ensuring that land resources are used efficiently and responsibly for current and future generations.
Symbiosis
Symbiosis
A close and often long-term interaction between two different biological species, which can be mutualistic, commensal, or parasitic.
Systems Biology
Systems Biology
An interdisciplinary field that focuses on complex interactions within biological systems, integrating data from various omics fields to understand how biological systems function.
T
Tailings
Tailings
The waste materials left over after the extraction of valuable minerals from ore, often stored in tailings ponds.
Tire Additive
Tire Additive
A substance added to tire formulations to enhance performance characteristics, such as durability, heat resistance, and longevity.
Toxicity
Toxicity
The degree to which a substance can harm living organisms.
Toxicity Testing
Toxicity Testing
The process of assessing the harmful effects of chemicals on living organisms, which is crucial for understanding the risks associated with CECs.
Toxicology
Toxicology
The study of the adverse effects of chemicals on living organisms.
Transcription
Transcription
The process by which the information in a gene is copied into messenger RNA (mRNA), which serves as a template for protein synthesis.
Transcriptomics
Transcriptomics
The study of the complete set of RNA transcripts produced by the genome under specific circumstances or in a specific cell type, providing insights into gene expression.
Translation
Translation
The process by which ribosomes synthesize proteins using the information encoded in mRNA.
Transmission
Transmission
The process by which an infectious agent, such as a virus, bacterium, or parasite, is spread from one host to another or from an environment to a host.
Transpiration
Transpiration
The release of water vapor from plants into the atmosphere, part of the larger process of evapotranspiration.
Trophic Levels
Trophic Levels
The hierarchical levels in an ecosystem based on feeding relationships, including producers, primary consumers, secondary consumers, and decomposers.
U
Unconfined Aquifer
Unconfined Aquifer
An aquifer that is directly replenished by surface water and is not capped by a layer of impermeable rock, allowing water to flow freely in and out.
Underground Mining
Underground Mining
A method of mining that involves extracting minerals from beneath the earth's surface.
Urban Planning
Urban Planning
The process of designing and regulating the development of urban areas to create sustainable, functional, and livable communities.
V
Vancomycin-Resistant Enterococcus (VRE)
Vancomycin-Resistant Enterococcus (VRE)
A type of bacteria that has developed resistance to vancomycin, an antibiotic commonly used to treat serious infections.
Vector
Vector
An organism, often an insect, that transmits pathogens from one host to another.
Vector-Borne Disease
Vector-Borne Disease
Diseases transmitted by vectors like mosquitoes, ticks, or fleas, including Lyme disease and malaria.
Virulence
Virulence
The degree of pathogenicity of a microbe, often measured by its ability to cause disease and the severity of the disease it produces.
Virus
Virus
A small infectious agent that can only replicate inside the living cells of an organism; viruses can infect all forms of life.
Volatile Organic Compounds (VOCs)
Volatile Organic Compounds (VOCs)
Organic chemicals that can evaporate into the air and contribute to air pollution; commonly found in paints and solvents.
W
Wastewater
Wastewater
Water that has been used in domestic, industrial, or commercial activities and is no longer suitable for its original purpose without treatment. It typically contains various contaminants, including organic matter, pathogens, chemicals, and nutrients. Wastewater can originate from sources such as households (sewage), industries (industrial effluents), and stormwater runoff.
Wastewater Treatment
Wastewater Treatment
The process of removing contaminants from wastewater before it is released into the environment, which may not effectively eliminate all CECs.
Water Quality
Water Quality
The physical, chemical, and biological characteristics of water, indicating its suitability for a specific use, such as drinking, recreation, or irrigation.
Water Table
Water Table
The upper surface of an unconfined aquifer, where the soil or rock is saturated with water.
Watershed
Watershed
An area of land where all rainfall and runoff flow into a common outlet, such as a river, lake, or ocean.
Wildlife Disease
Wildlife Disease
Any disease that affects wild animal species, potentially impacting their health, population dynamics, and ecosystems.
Wildlife Habitat Management
Wildlife Habitat Management
Practices aimed at maintaining or enhancing habitats to support wildlife populations and biodiversity.
Z
Zoning
Zoning
The legal process of dividing land into zones to regulate the use of land and buildings, ensuring compatibility between different land uses.
Zoonosis
Zoonosis
Any disease that can be transmitted from animals, including wildlife, to humans.
Zoonotic Disease
Zoonotic Disease
A disease that can be transmitted from animals to humans.

